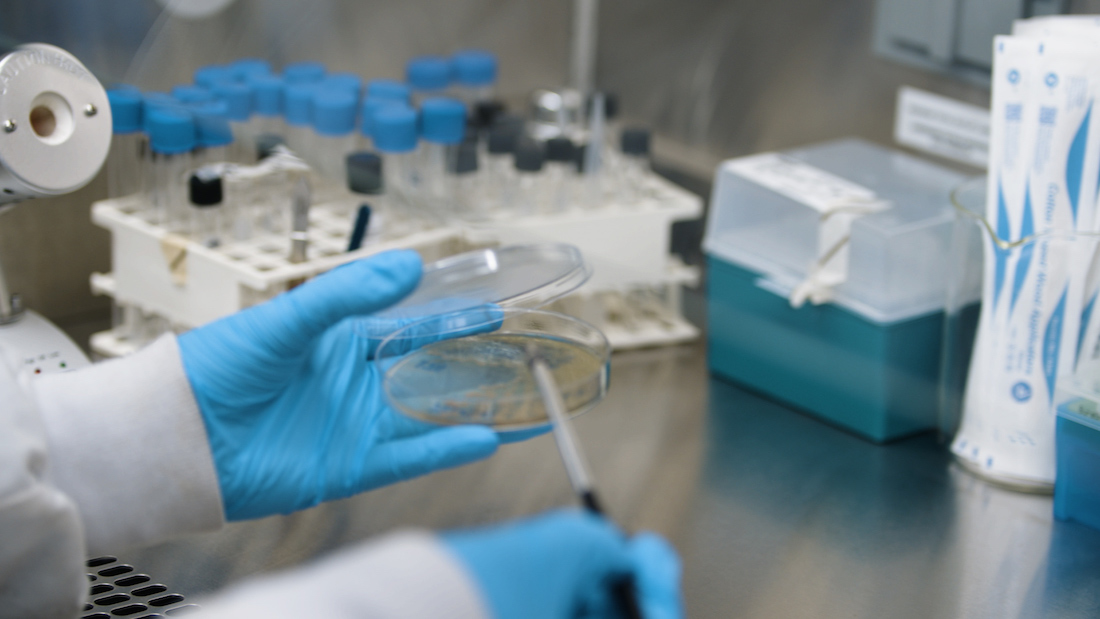

Pourriez-vous, pour commencer, nous présenter A3 Surfaces ?
Martin Lambert : Tout commence en 2009, lorsque deux chercheurs au sein du laboratoire québécois Ecogène-21, ont développé un procédé d’anodisation de l’aluminium permettant d’obtenir des pièces antimicrobiennes, autodésinfectantes et efficaces à 99,9 % dès les premières secondes de contact avec des pathogènes. Cette technologie en instance de brevet a été suivie dès 2015 par la fondation d’AS Surfaces, qui conçoit depuis des produits visant à prévenir les contaminations croisées et les infections associées aux soins. Nous comptons d’ailleurs créer à terme une unité de production en Europe.
Comment fonctionne plus concrètement votre technologie ?
Appliquée à une surface d’aluminium désoxydée, l’anodisation consiste à y créer, par un procédé électrochimique, plus d’un milliard de nanostructures au cm2. Cette première étape, dite d’anodisation dure, permet d’obtenir une pièce particulièrement résistante aux égratignures et à l’usure dans le temps, offrant donc une durée de vie quasi illimitée. Des substances antimicrobiennes sont ensuite liées aux nanostructures précédemment créées : des quantités incalculables de molécules biocides au cm2 sont alors capables de capter et de détruire immédiatement tout micro-organisme potentiellement pathogène, plutôt que d’en inhiber simplement le développement, comme cela est le cas pour d’autres technologies. Le procédé est toutefois sans danger pour l’homme et l’environnement, comme l’ont démontré nos nombreux tests de biotoxicité. Comme je le soulignais, l’aluminium ainsi créé est à la fois antimicrobien et autodésinfectant, et ce de manière quasi permanente. Son efficacité immédiate le démarque grandement des autres métaux biocides, dont l’action nécessite plusieurs heures.
AS Surfaces vient de s’implanter en France. Quels sont vos projets à court et moyen terme ?
À la suite de notre participation récente à SantExpo, nous avons en effet eu de nombreuses demandes de la part d’établissements de santé français pour cette technologie écoresponsable et à l’efficacité remarquable. Nous avons donc créé une filiale française et ouvert un centre de distribution en région parisienne, afin de répondre rapidement aux sollicitations. Je m’y installe d’ailleurs moi-même et compte bien développer de nouveaux liens avec les directions hospitalières, les hygiénistes, les architectes et maîtres d’ouvrage, etc. Nous inaugurerons en outre prochainement un showroom, et travaillons déjà avec les adhérents de la centrale d’achat CAHPP – où nos produits sont référencés – pour recréer un parcours patient et un parcours d’agent hospitalier au sein d’un établissement de santé. Nous pourrons ainsi identifier les surfaces à équiper au cours des différentes étapes, pour une action autodésinfectante immédiate mais aussi une action préventive. Cela dit, nos produits ne remplacent pas le bionettoyage, qui reste nécessaire. Ils offrent néanmoins une sécurité supplémentaire tout en réduisant la charge de travail des opérateurs et les coûts liés à l’utilisation des produits chimiques – offrant dès lors de nouvelles sources d’économies. Nous continuerons donc d’enrichir notre catalogue, qui recense déjà une dizaine de produits – plaques à pousser, barres d’appui, mains courantes, surfaces de travail, poignées de porte, dessus de boîtes de gants, etc.
> Plus d'informations sur le site d'A3 Surfaces
Article publié dans l'édition de septembre 2022 d'Hospitalia à lire ici.
Martin Lambert : Tout commence en 2009, lorsque deux chercheurs au sein du laboratoire québécois Ecogène-21, ont développé un procédé d’anodisation de l’aluminium permettant d’obtenir des pièces antimicrobiennes, autodésinfectantes et efficaces à 99,9 % dès les premières secondes de contact avec des pathogènes. Cette technologie en instance de brevet a été suivie dès 2015 par la fondation d’AS Surfaces, qui conçoit depuis des produits visant à prévenir les contaminations croisées et les infections associées aux soins. Nous comptons d’ailleurs créer à terme une unité de production en Europe.
Comment fonctionne plus concrètement votre technologie ?
Appliquée à une surface d’aluminium désoxydée, l’anodisation consiste à y créer, par un procédé électrochimique, plus d’un milliard de nanostructures au cm2. Cette première étape, dite d’anodisation dure, permet d’obtenir une pièce particulièrement résistante aux égratignures et à l’usure dans le temps, offrant donc une durée de vie quasi illimitée. Des substances antimicrobiennes sont ensuite liées aux nanostructures précédemment créées : des quantités incalculables de molécules biocides au cm2 sont alors capables de capter et de détruire immédiatement tout micro-organisme potentiellement pathogène, plutôt que d’en inhiber simplement le développement, comme cela est le cas pour d’autres technologies. Le procédé est toutefois sans danger pour l’homme et l’environnement, comme l’ont démontré nos nombreux tests de biotoxicité. Comme je le soulignais, l’aluminium ainsi créé est à la fois antimicrobien et autodésinfectant, et ce de manière quasi permanente. Son efficacité immédiate le démarque grandement des autres métaux biocides, dont l’action nécessite plusieurs heures.
AS Surfaces vient de s’implanter en France. Quels sont vos projets à court et moyen terme ?
À la suite de notre participation récente à SantExpo, nous avons en effet eu de nombreuses demandes de la part d’établissements de santé français pour cette technologie écoresponsable et à l’efficacité remarquable. Nous avons donc créé une filiale française et ouvert un centre de distribution en région parisienne, afin de répondre rapidement aux sollicitations. Je m’y installe d’ailleurs moi-même et compte bien développer de nouveaux liens avec les directions hospitalières, les hygiénistes, les architectes et maîtres d’ouvrage, etc. Nous inaugurerons en outre prochainement un showroom, et travaillons déjà avec les adhérents de la centrale d’achat CAHPP – où nos produits sont référencés – pour recréer un parcours patient et un parcours d’agent hospitalier au sein d’un établissement de santé. Nous pourrons ainsi identifier les surfaces à équiper au cours des différentes étapes, pour une action autodésinfectante immédiate mais aussi une action préventive. Cela dit, nos produits ne remplacent pas le bionettoyage, qui reste nécessaire. Ils offrent néanmoins une sécurité supplémentaire tout en réduisant la charge de travail des opérateurs et les coûts liés à l’utilisation des produits chimiques – offrant dès lors de nouvelles sources d’économies. Nous continuerons donc d’enrichir notre catalogue, qui recense déjà une dizaine de produits – plaques à pousser, barres d’appui, mains courantes, surfaces de travail, poignées de porte, dessus de boîtes de gants, etc.
> Plus d'informations sur le site d'A3 Surfaces
Article publié dans l'édition de septembre 2022 d'Hospitalia à lire ici.